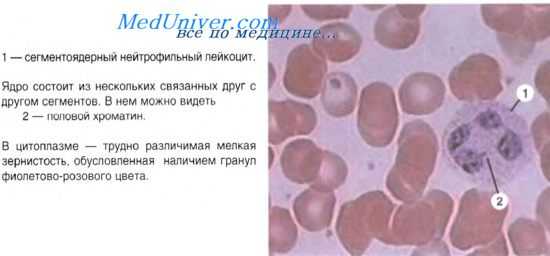
эритроциты крови

Состав крови. Плазма. Эритроциты.
Добавил пользователь Евгений Кузнецов Обновлено: 12.12.2025
Кровь. Плазма крови. Эритроциты человека.
Кровь — ткань внутренней среды защитно-трофической функции, состоящая из жидкого межклеточного вещества (плазмы), постклеточных структур (эритроцитов и тромбоцитов) и клеток как периферической крови и лимфы, так и клеток на всех стадиях своего развития в кроветворных органах. Клеточные и постклеточные структуры периферической крови называются форменными элементами. Объем крови в организме человека равен 5-5,5 л (или около 7% массы тела), при этом форменные элементы составляют 40-45%, а плазма — 55-60%.
Кровь выполняет следующие функции: 1) трофическую — перенос питательных веществ ко всем клеткам и тканям; 2) дыхательную — газообменную, или транспорт кислорода к тканям и удаление из организма углекислоты; 3) защитную (фагоцитоз, выработка антител); 4) регуляторную — транспорт гормонов и других гуморальных факторов регуляции; 5) гомеостатическую — поддержание физико-химического постоянства состава внутренней среды организма.
Плазма крови — это жидкое межклеточное вещество (рН 7,34-7,36), в котором во взвешенном состоянии находятся форменные элементы крови. 93% плазмы составляет вода, остальное — белки (альбумины, глобулины, фибриноген и десятки других), липиды, углеводы, минеральные вещества. При свертывании крови фибриноген переходит в нерастворимый белок — фибрин. Оставшаяся жидкая часть плазмы после свертывания фибриногена называется сывороткой. В сыворотке содержатся антитела (иммуноглобулины).
Форменные элементы крови представляют собой гетероморфную систему, состоящую из различно дифференцированных в структурно-функциональном отношении элементов. Объединяют их общность гистогенеза и совместное пребывание в периферической крови.
Количество эритроцитов в 1 л крови составляет — 4-5,5х10 12 у мужчин и 3,7-4,9х10 12 у женщин. Число эритроцитов может изменяться при разных физиологических состояниях организма и региональных особенностях проживания. Стойкое повышение их числа называется эритроцитозом, уменьшение — эритропенией. Диагностическое значение имеет скорость оседания (агглютинация) эритроцитов (СОЭ). В норме у мужчин СОЭ равна 4-8 мм в час, у женщин — 7-10 мм в час.
Покровная и рецепторно-трансдукторная системы эритроцита характеризуются рядом особенностей. Плазмолемма имеет толщину 20 нм. В ней хорошо развиты транспортные процессы за счет ионных насосов, каналов и белковых переносчиков. Она обладает избирательной проницаемостью, обеспечивает перенос кислорода, двуокиси углерода, ионов натрия и калия, но не препятствует соединению гемоглобина с окисью углерода (угарным газом). Свойства плазмолеммы позволяют эритроциту без повреждения проходить через капилляры, диаметр которых меньше диаметра самого эритроцита. Гликокаликс плазмолеммы, образованный гликолипидами и гликопротеинами, содержит агглютиногены А и В, определяющие групповую принадлежность крови. Наличие в гликокаликсе аглютиногена — резус фактора, определяет принадлежность человека к резус-положительной (86 % людей имеют этот фактор) или резус-отрицательной популяциям.
Рецепторную функцию выполняют трансмембранные гликопротеины — гликофорины, обеспечивающие индивидуальные для каждого человека антигенные характеристики эритроцитов.
Двояковогнутая форма эритроцита поддерживается благодаря белкам опорно-двигательной системы, в частности спектрина, формирующего в примембранном пространстве эритроцита сеть филаментов, и некоторых других белков.
Основную массу эритроцита составляют вода (66%) и белок — гемоглобин (33%). Под электронным микроскопом содержимое эритроцитов выглядит очень плотным. В нем определяются многочисленные гранулы гемоглобина диаметром 4-5 нм. Гемоглобин — дыхательный пигмент. Белковая часть его называется глобин, железосодержащая часть — гем, который составляет 4-5% от массы гемоглобина и придает желтую окраску эритроциту. Гемоглобин легко присоединяет кислород воздуха, превращаясь в оксигемоглобин. Это происходит в капиллярах легких. В онтогенезе свойства гемоглобина, меняются, в связи с чем различают гемоглобин эмбриональный (фетальный) и гемоглобин взрослых. Благодаря накоплению гемоглобина при эритропоэзе эритроциты и выполняют дыхательную функцию. Наряду с транспортом кислорода и других веществ (аминокислот, антител, токсинов) эритроциты переносят двуокись углерода из тканей в легкие. Наличием гемоглобина обусловлена оксифилия эритроцитов, т. е. сродство к кислым красителям.
В гипотонической среде гемоглобин выходит из эритроцитов в результате поступления в них воды и разрыва оболочки. Выход гемоглобина называется гемолизом. Некоторые вещества (например, фенилгидразин) вызывают гемолиз. После удаления из эритроцита гемоглобина остается строма — бесцветная масса (или "тень" эритроцита).
Количество циркулирующих в организме эритроцитов составляет около 25-30х10 12 . Появлению эритроцитов в крови предшествует длинный путь эритроцитопоэза. В кровь поступают наряду со зрелыми эритроцитами и молодые, бедные гемоглобином формы — ретикулоциты, составляющие 1-2%.В них сохраняются некоторые органеллы, которые при окраске мазков метиленовым синим выявляются в виде базофильных сетчатых структур. Возрастание числа ретикулоцитов наблюдается при гипоксии, кровопотере и др.
Эритроциты живут в крови от 70 до 120 суток. Продолжительность жизни эритроцитов может сокращаться до 24 суток (например, при занятии "моржеванием"). Ежесуточно распадается около 200 млрд. эритроцитов. Разрушение их происходит в основном в селезенке и красном костном мозге. Специальные клетки — макрофаги захватывают эритроциты и обеспечивают реутилизацию (повторное использование) железа при развитии новых генераций эритроцитов.
Состав крови
Все эти клетки взвешены в плазме крови, которая не только является транспортной средой для кровяных клеток, перемещая их по человеческому телу, но и содержит необходимые организму белки и соли.
Красные кровяные клетки - эритроциты
Красные кровяные клетки выполняют одну из важных функций крови. В капле крови содержатся миллионы эритроцитов, которые постоянно циркулируют по кровеносным сосудам, доставляя к органам кислород и удаляя образующийся в процессе клеточного дыхания углекислый газ.
Эритроциты называют красными кровяными клетками, потому что они содержат белок гемоглобин, имеющий ярко красный цвет. Именно гемоглобин переносит кислород и углекислый газ. Когда кровь проходит через легкие, молекулы кислорода присоединяются к гемоглобину, который доставляет его к каждой клеточке нашего тела. Освободившись от кислорода, гемоглобин присоединяет к себе молекулы углекислого газа. В легких, углекислый газ освобождается и выводится с дыханием из организма.
Средний срок жизни эритроцита составляет 120 дней. Костный мозг постоянно производит клетки крови, восполняя их естественную убыль.
Белые кровяные клетки - лейкоциты
Лейкоциты исполняют защитные функции, как только в организм проникает инфекция в дело вступают белые кровяные клетки - лейкоциты. Лейкоциты постоянно находятся на страже. Некоторые лейкоциты (лимфоциты) производят защитные антитела – белки, нейтрализующие или уничтожающие вирусы и болезнетворные бактерии.
Жизненный цикл лейкоцитов сравнительно короток - от нескольких дней, до нескольких недель. В одном кубике крови здорового человека содержится от 4 до 8 тысяч лейкоцитов. Если организм борется с инфекцией, это число может увеличиться. Постоянное слишком большое или слишком малое количество лейкоцитов в крови может свидетельствовать о наличии серьёзных заболеваний.
Тромбоциты
Человек очень тяжело переносит массированную кровопотерю. Однако наш организм имеет механизм, защищающий его от потери крови, и основную роль в этом механизме играют тромбоциты.
Тромбоциты представляют собой бесцветные тельца неправильной формы, циркулирующие в крови. Они обладают способностью формировать сгустки (тромбы), останавливающие кровотечение.
Если началось кровотечение, то тромбоциты собираются у раны и пытаются блокировать кровотечение. Кальций, витамин К и белок фибриноген помогают тромбоцитам сформировать сгусток закрывающий кровоточащий сосуд. По мере высыхания, сгусток твердеет, образуя хорошо всем известную «корочку».
Плазма
Плазма представляет собой прозрачную, окрашенную в соломенный цвет жидкость, на 90% состоящую из воды, и является исключительно важным компонентом крови.
Кроме воды плазма содержит в своём составе (приблизительно 1% от объёма) растворённые соли кальция, калия, фосфорной кислоты, натрия. Около 7% объёма плазмы составляют белки. Среди них фибриноген, принимающий участие в свертывании крови. В плазме крови есть глюкоза, а также другие питательные вещества и продукты распада.
Состав крови. Плазма. Эритроциты.
В среднем у взрослого человека содержится около 5 л крови. Чисто формально можно сказать, что кровь представляет собой жидкую ткань. Она образована клетками (форменными элементами крови) нескольких типов, взвешенными в жидком матриксе, называемом плазмой. Чтобы увидеть клетки крови под микроскопом, делают ее мазок. На долю клеток приходится примерно 45% ее объема, остальные 55% составляет плазма. Если кровь центрифугировать, то клетки (в том числе и тромбоциты, являющиеся на самом деле клеточными фрагментами) образуют на дне пробирки красный осадок, поверх которого будет находиться светло-желтая плазма.
Плазма, из которой удален белок фибриноген (он необходим для свертывания крови), называется сывороткой. рН крови варьирует от 7,35 до 7,45.
В этой статье мы рассмотрим состав крови и вкратце ее функции, которые более подробно обсуждаются в нашей статье.
Плазма
Плазма представляет собой жидкость светло-желтого цвета, 90% которой составляет вода, а остальное приходится на различные растворенные и взвешенные в ней вещества. Основные компоненты плазмы с краткой характеристикой их функций приведены в таблице. Из растворенных компонентов в плазме больше всего содержится натрий-ионов. Подробнее функции плазмы рассмотрены в нашей статье.

Клетки крови. Эритроциты (красные кровяные клетки)
Эритроциты человека — это мелкие клетки, лишенные в зрелом состоянии ядра и имеющие форму двояковогнутых дисков. Средний диаметр эритроцитов составляет 7—8 мкм (диаметр средней клетки животного равен примерно 20 мкм) а толщина — примерно 2,2 мкм. Особенности их формы обеспечивают большее, чем у сферы, отношение поверхности к объему, а следовательно, увеличивают доступную для газообмена поверхность. Толщина отдельного эритроцита очень мала и это облегчает диффузию газов с поверхности внутрь клетки. Благодаря эластичности своей мембраны эритроциты могут складываться наподобие зонтика, что позволяет им протискиваться через капилляры, просвет которых меньше диаметра эритроцита. В 1 мм3 крови (объем капли составляет примерно 50 мм3) содержится около 5 млн. эритроцитов. Эта цифра, однако, варьирует в зависимости от возраста, пола и состояния здоровья индивидуума. Эритроциты составляют почти половину объема крови, что объясняет ее очень высокую способность связывать кислород — приблизительно 20 мл 02 на 100 мл, другими словами, кислородная емкость крови равна 20%.
Эритроциты содержат большое количество гемоглобина — переносящего кислород белкового пигмента, который и придает крови красный цвет. В клетках эритроцитов отсутствуют ядра. (В эритроцитах нет также митохондрий. Это не только высвобождает дополнительное место для гемоглобина, но и заставляет их дышать анаэробно, т. е. не потребляя кислород, который они переносят.) Гемоглобин обратимо связывает кислород (превращаясь в оксигемоглобин) в местах с высокой его концентрацией и отдает его в местах с низкой концентрацией. Эритроциты содержат также фермент карбоангидразу, участвующий в транспорте ими диоксида углерода.
Продолжительность жизни эритроцитов у взрослого человека сравнительно невелика — примерно три месяца (объясняется это отсутствием ядра, регулирующего процессы репарации в клетке), после чего они разрушаются в селезенке или в печени. Белковая часть эритроцита при этом расщепляется до аминокислот, а железо высвобождается из небелковой (пигментной) части гемоглобина, называемой гемом, и запасается в печени в составе железосодержащего белка ферритина. Затем железо может использоваться повторно при образовании новых эритроцитов или для синтеза ци-тохромов. Остальная часть молекулы тема расщепляется с образованием двух желчных пигментов — красного билирубина и зеленого биливердина. Они выводятся в кишечник в составе желчи.
Каждую секунду в организме человека разрушается и замещается новыми от 2 до 10 млн. эритроцитов. Каждый из них содержит примерно 250 млн. молекул гемоглобина. Это крупный белок, так что можно представить, насколько интенсивно должен идти в организме белковый синтез хотя бы для поддержания дыхательной функции крови. Скорость разрушения и замещения эритроцитов частично зависит от содержания кислорода в атмосфере. Если его количество, попадающее в кровь из легких, невелико, то в костном мозге образуется больше эритроцитов, чем их гибнет в печени. Это один из путей нашей адаптации к недостатку кислорода на больших высотах. Следовательно, альпинистам перед штурмом вершины да и любым спортсменам перед соревнованиями в горах необходим период высотной акклиматизации. При высоком содержании кислорода в воздухе наблюдается обратная картина.
Информация на сайте подлежит консультации лечащим врачом и не заменяет очной консультации с ним.
См. подробнее в пользовательском соглашении.
Общий анализ крови в норме. Что значат отклонения?
Общий анализ крови является основополагающим исследованием в диагностике любого заболевания. За счет многочисленных функций крови (доставка кислорода и питательных веществ, отвод продуктов обмена, защита внутренней среды организма и поддержания ее постоянства) и ее особенностей как ткани, кровь за счет своей динамичности самой первой реагирует на любые изменения в теле человека. Именно поэтому по общему анализу крови можно значительно сузить поиск предполагаемых патологий и в некоторых случаях даже сразу диагностировать различные заболевания.
Несмотря на свою динамичность, основные показатели крови в норме у разных людей находятся примерно на одном уровне в довольно узких рамках. Поэтому значение нормы общего анализа крови выглядит примерно так:

Изменение любого из основных показателей общего анализа крови с одной стороны является признаком какого-либо нарушения в организме, с другой - такое изменение одного показателя может вызывать нарушения в других системах, что ведет к еще большему расшатыванию организма, что также находит отражение в общем анализе крови.
Более часто встречается снижение количества эритроцитов, которое называется эритроцитопения. Это состояние может развиться по двум основным причинам - из-за усиленного распада и потери эритроцитов (при гемолитической анемии, кровотечениях, онкологических заболеваниях, некоторых отравлениях) или при недостаточном их образовании - при недостатке в пище белков, железа, некоторых витаминов, таких как С, В12.
Скорость оседания эритроцитов (СОЭ, ESR) - важный показатель, характеризующий взаимоотношения между белками плазмы крови и мембраной эритроцитов. Белковый состав плазмы крови очень сильно меняется при воспалительных процессах в организме, что облегчает склеивание эритроцитов и они выпадают в осадок. Поэтому традиционно СОЭ является главным индикатором воспаления. При остром воспалении данный показатель повышается до 40-50 мм/ч. В тоже время, у беременных женщин значение СОЭ сохраняется на уровне 20-25 мм/ч, что не является признаком патологии, а скорее особенностью этого периода.
Гемоглобин (Hb) является главным пигментом крови и содержится в эритроцитах. Именно его железосодержащие молекулы способны связывать и транспортировать газы в крови. Количество гемоглобина прямо коррелируется с такими значениями общего анализа крови, как количество эритроцитов и цветовой показатель. Снижение количества гемоглобина называется анемией и характеризуется значительным нарушением питания органов и тканей. Главными причинами анемии выступают неправильное питание (недостаток железа, белков и витаминов в рационе), длительные изнуряющие заболевания, болезни системы крови. Также количество гемоглобина уменьшается после кровопотери, в том числе и после менструаций у женщин. Иногда даже обильные менструации приводят к хронической анемии.
Цветовой показатель - условное значение, характеризующее содержание гемоглобина в одном эритроците. Нормальное содержание данного пигмента в одной клетке принято за единицу, колебания вокруг этой физиологической нормы составляют от 0,85 до 1,15. Снижение цветового показателя (гипохромия) сопровождает большинство видов анемий, в основном при недостаточном поступлении или усвоении железа (железодефицитная анемия) или при хронической кровопотере (хроническая постгеморрагическая анемия) - при этом недостаток гемоглобина может наблюдаться даже при нормальном количестве эритроцитов. Единственный случай повышение цветового показателя - гиперхромная анемия, которая возникает в результате дефицита витамина В12. При этом в общем анализе крови также будут выявлены аномальные формы эритроцитов - макроциты и мегалоциты.
Ретикулоциты (RTC) представляют собой молодые эритроциты, только что выделенные из красного костного мозга. Их выделяют в общем анализе крови для определения активности кроветворной системы. Так, снижение количества ретикулоцитов - ретикулоцитопения - означает остановку в работе красного костного мозга, что со временем ведет к анемии. Повышение же этого показателя свидетельствует об активизации кроветворной системы и встречается после кровопотери, при переезде в горную местность, после начала лечения анемии различного происхождения.

Гематокрит является соотношением объемов эритроцитов и плазмы крови, выраженное в процентах. Этот показатель используют в качестве индикатора водного обмена, а также при выяснении причин повышенного или пониженного содержания эритроцитов крови. Гематокрит имеет тенденцию к повышению эритроцитозе и к уменьшению - при анемиях и эритроцитопениях.
Тромбоциты (PLT) или кровяные пластинки являются основным звеном свертывающей системы крови, поэтому значение этого показателя общего анализа крови исключительно важно. При его снижении (тромбоцитопении) развивается геморрагический синдром (частые синяки, кровотечения из десен и носа, кровоподтеки на коже), причиной снижения может быть отравление различными веществами, поражение косного мозга, некоторые аутоиммунные, генетические и онкологические заболевания. Повышение количества тромбоцитов или тромбоцитоз возникает в ответ на кровотечение, после хирургических вмешательств, на заключительных этапах беременности.
Лейкоцитами (Le) или белой кровью называют комплекс иммунокомпетентных клеток, которые обеспечивают защиту организма от чужеродной информации. Большое диагностическое значение имеет изменение количества как всех лейкоцитов, так и отдельных их разновидностей. Снижение количества лейкоцитов (лейкопения) в общем анализе кровихарактеризуется снижением иммунной защиты организма и развивается при некоторых инфекционных заболеваниях, ВИЧ-инфекции, при поражении костного мозга или истощении организма. Лейкоцитоз или повышение количества лейкоцитов возникает как реакция на заражение организма различными инфекционными агентами, также при здоровом организме появляется у беременных женщин, после приема пищи, тяжелой физической нагрузки - именно поэтому наиболее правильный общий анализ крови получается при сдаче утром натощак. Значительные повышения уровня лейкоцитов - в десятки и сотни раз выше нормы - являются признаком злокачественного заболевания крови - лейкоза или лейкемии.
Эозинофилы (EOS) служат индикатором аллергических процессов, так как разрушают гистамин, который массово выделяется при любой аллергии. Поэтому повышение уровня эозинофилов (эозинофилия) означает наличие непереносимости, аллергических заболеваний (пищевой аллергии, бронхиальной астмы), а также является признаком наличия в организме паразитов-гельминтов. Снижение же количества этих клеток наблюдается при эндокринных заболеваниях (гипотиреоз, синдром Иценко-Кушинга), при остром аппендиците.
Базофилы (BAS) и моноциты по современным представлениям представляют собой не постоянных "жителей" кровеносного русла, а находятся там лишь при транспортировке в органы и ткани, где становятся тканевыми базофилами и макрофагами. Изменение их количества практически не представляет ценность для диагностики, так как происходит в комплексе с другими лейкоцитами.
Нейтрофилы (NEU) или микрофаги являются главным компонентом защиты организма от бактерий и других клеточных микроорганизмов. В общем анализе крови выделяют три разновидности этих лейкоцитов, которые, по сути, являются одними и теми же нейтрофилами на разных стадиях зрелости. Юные нейтрофилы в норме отсутствуют в периферической крови, их появление свидетельствует о начале острого воспалительного процесса (нейтрофильный сдвиг влево). Увеличение количества же зрелых сегментоядерных нейтрофилов (нейтрофильный сдвиг вправо) свидетельствует о перенесенном инфекционном заболевании, поражении костного мозга (при одновременном уменьшении палочкоядерных форм), некоторых онкологических заболеваниях.
Лимфоциты (LYM) обеспечивают противовирусный и противоопухолевый иммунитет. Уменьшение их количества сопровождается снижением защитных сил организма и возникает при истощении, иммунодефиците и ВИЧ-инфекции, поражении костного мозга и вилочковой железы. Количество лимфоцитов повышается (лимфоцитоз) в качестве ответа на вирусную и другую инфекцию. Сильное повышение может быть признаком лимфомы - опухоли клеток лимфатической ткани.
Конечно же, отдельно взятый показатель общего анализа крови редко дает однозначный ответ и способствует постановке диагноза, все эти показатели дополняют друг друга. Так, повышение СОЭ вместе с левым нейтрофильным сдвигом свидетельствует об острой бактериальной инфекции, а такое же СОЭ при лейкоцитозе без сдвига - о застарелой или хронической инфекции. Изучение всех вариантов взаимодействия всех компонентов общего анализа крови требует глубоких знаний, поэтому его расшифровкой может заниматься только опытный врач.
Учебное видео - общий анализ крови в норме и при болезни
- Рекомендуем посетить наш раздел с интересными материалами на аналогичные тематики "Профилактика заболеваний"
Что нужно знать о составе крови

Из чего состоит кровь? Рассказываем о ее основных компонентах – плазме, эритроцитах, лейкоцитах и тромбоцитах.
Кровь – это один из типов соединительной ткани, дальний родственник костей, хрящей и даже жира. Она циркулирует по всему телу при помощи сердца и сосудов и имеет две основные функции: транспортировка питательных веществ и кислорода к клеткам и защита от инфекционных агентов, в том числе бактерий и вирусов. Из чего состоит кровь? Давайте поговорим о ее основных компонентах – плазме, эритроцитах, лейкоцитах и тромбоцитах.
Это основной компонент крови, составляющий около 55 процентов ее объема. Плазма крови состоит из воды, различных солей и белков. Она помогает в транспортировке сахаров, жиров, гормонов, витаминов и ферментов к тканям организма.
Донорская кровь требуется каждый день. Узнайте, почему донорство крови так необходимо и как подготовиться к сдаче крови.
Эритроциты
Их также называют красными кровяными тельцами. Эритроциты – наиболее распространенный тип клеток крови, и именно они придают ей красный цвет. В одном кубическом миллилитре крови содержится около пяти миллионов эритроцитов. У этих клеток нет ядра, но они содержат миллионы молекул гемоглобина. Этот железосодержащий белок связывает молекулы кислорода, полученные в легких, и транспортирует его по всему организму. После того, как кислород доставлен в клетки организма, эритроциты забирают у них углекислый газ и переносят его в легкие, чтобы вывести из организма при помощи легких. Эритроциты производятся в красном костном мозге костей черепа, ребер и позвоночника. Ежедневно в организме производится более двух с половиной миллионов эритроцитов, и примерно такое же количество этих клеток гибнет. Продолжительность жизни одного эритроцита – около трех месяцев. Если красных кровяных клеток, переносящих кислород и удаляющих углекислый газ из тканей, производится недостаточно – развивается анемия. Для нее характерно ощущение слабости, быстрая утомляемость и недостаток внимания. В более тяжелых случаях может появиться одышка, учащенное сердцебиение и нарушение сна. Внимание! Если вы наблюдаете подобные симптомы в течение продолжительного времени, обязательно обратитесь к врачу.
Лейкоциты
Белые кровяные тельца – лейкоциты – играют важную роль в работе иммунной системы организма, защищая его от инфекции. Они обнаруживают, уничтожают и выводят из организма патогенные микроорганизмы, вредные и токсичные вещества. Кроме того, лейкоциты способны бороться с раковыми клетками. Существует несколько типов белых кровяных телец, каждый из которых обладает своими уникальными функциями. Моноциты вырабатываются в костном мозге и составляют от трех до восьми процентов от общего объема всех белых клеток крови. Моноциты способны превращаться в другие клетки крови – макрофаги и дендритные клетки. Моноциты, превратившиеся в макрофаги, уничтожают обнаруженных в организме «захватчиков» – в том числе бактерий и паразитов. Кроме того, макрофаги поглощают клеточный мусор и мёртвые клетки, зараженные вирусами. Поглотив их, макрофаги способны «поднять тревогу», передав другим клеткам иммунной системы информацию о заражении. Дендритные клетки помогают работе адаптивной иммунной системы, которую также называют «приобретенным иммунитетом». Они не уничтожают чужеродные элементы самостоятельно, но помогают определять их как враждебные и «учат» этому другие клетки крови. Эта важная информация сохраняется – в дальнейшем, встретив знакомого «захватчика», клетки реагируют быстрее и эффективнее. Нейтрофилы производятся в костном мозге и составляют от 50 до 70 процентов всех кровяных клеток. Эти клетки реагируют на появление инфекции первыми – в течение часа после заражения. Нейтрофилы борются не только с инфекциями во внутренних органах, но и на поверхности кожи. Например, гной, который является одним из видимых признаков воздействия инфекции, состоит в основном из мертвых нейтрофилов и бактерий. Эозинофилы также производятся в костном мозге и составляют от одного до трех процентов всех белых кровяных клеток. Эозинофилы циркулируют не только в кровеносных сосудах – их можно обнаружить в различных органах. Например, в желудочно-кишечном тракте содержится наибольшее количество эозинофилов. Эти клетки убивают бактерии и паразиты. К сожалению, они могут принять за «захватчика» даже полезные вещества, взывая аллергическую реакцию и воспаление.
Через кровь передаются такие вирусы, как гепатит С и ВИЧ. Узнайте больше о том, как избежать заражения.
B-клетки также производятся в костном мозге, но покидают его незрелыми. Они развиваются в полнофункциональные В-клетки, только достигнув органов лимфатической системы – селезенки и лимфоузлов. После этого В-клетки циркулируют в крови, выполняя функции «иммунного надзора». Один тип В-клеток способен прикрепляться к «захватчику» и работать маркером, чтобы другие клетки иммунной системы правильно их распознали. Второй тип В-клеток отвечает за выработку антител. В-клетки живут долго и обладают своеобразной «памятью». Они распознают инфекции, с которыми организм встречался раньше, и помогают иммунной системе распознать и уничтожить их намного быстрее. Т-клетки также способны к «обучению». Они умеют распознавать бактерии, вирусы и даже раковые клетки, если те ранее появлялись в организме. Т-клетки бывают двух основных видов: Т-хелперы и Т-киллеры. Т-хелперы реагируют на информацию об инфекции, полученную от макрофагов и дендритных клеток. Они начинают активно делиться и производят вещества для активации В-клеток и Т-киллеров. Т-киллеры атакуют клетки организма, которые заражены бактериями или вирусами. Киллеры «сканируют» каждую клетку и, обнаружив наличие инфекции, убивают ее.
Их еще называют кровяными пластинками. Тромбоциты регулируют свертываемость крови и защищают организм от кровотечений. Когда тромбоциты оказываются в просвете поврежденного сосуда, они слипаются и блокируют собой отверстие, не давая крови вытекать. Фото: wellcome images
Читайте также:
- Влияние секретина на синтез инсулина, на желудок и кровоток
- Дифференциальная диагностика дерматомиозита. Отличительные признаки
- Гипертонический криз. Причины ( этиология ) гипертонического криза. Патогенез, классификация гипертонического криза.
- Противопоказания для антиаритмических лекарственных средств
- Причины и признаки воспаления пищевода
